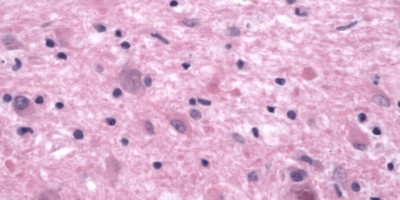
Reactive Astrocytes Reactive Astrocytes on pathology slide

Understanding neuroanatomy, histology, and physiology are integral for medical students who are laying the foundation of neurology. For residents and fellows, reviewing such material serves as a refresher of topics not regularly confronted in clinical practice but are often seen on in-service and board examinations. In this section, we will cover CNS histology, anatomy as well as briefly mention some associated neurological syndromes.
Authors: James Eaton MD, Steven Tessier, Brian Hanrahan MD
Central Nervous System Histology
Glial cells
- May be classified as macroglia (which include astrocytes, oligodendrocytes, and ependymal cells) and microglia.
- Provide support and protection for neurons.
- Glial cells outnumber neurons 10 to 1 in the central nervous system.
Astrocytes
- The largest glial cell.
- Support function of neurons in multiple ways:
- Regulates interstitial fluid.
- Modulates signals that regulate blood flow in response to neuronal activity.
- Provides structural support; astrocytes are essential components of the blood-brain barrier and of glial-limiting membranes (aka glial limitans) that line the pia matter and parenchymal vasculature.
- Provides nutritional support via glycogen storage.
- Protects against the death of neurons by activating antioxidant pathways.
Microscopic images of astrocytes

Oligodendrocytes
- Responsible for the formation of myelin in the central nervous system
- Myelin provides electrical insulation that allows for saltatory conduction, the speed of which is determined by the length of the internodal myelin segments. Larger axonal diameters conduct faster than smaller diameters.
- Oligodendrocytes have condensed, rounded nuclei and unstained cytoplasm.
Oligodendrocytes vs. Oligodendroglioma

Astrocyte-Oligodendrocyte crosstalk
- Communication occurs by direct cell-cell gap junctions, as well as secreted signaling molecules.
- The importance of astrocyte-oligodendrocyte communication is made apparent in primary astrocytopathies such as Alexander disease, and osmotic demyelination syndrome.
Ependymal cells
- Produces and facilitates the movement of cerebrospinal fluid (CSF).
- Lines the ventricles and central canal of the spinal cord.
- Resembles simple cuboidal or columnar epithelium with some cilia and microvilli on histopathology.
Microglia
- The primary immune cell of the central nervous system.
- Responsible for antigen presentation,
- Activates in response to tissue damage and ischemic injury. Once activated, becomes a motile, phagocytic cell (adept for neuronophagia) which forms reactive oxygen species and secretes cytokines and proteases.
- The smallest and rarest glial cell.
- Derived from bone marrow/monocytes and enter the CNS in the perinatal period.
- All other glial cells and neuronal cells are derived from neural tube cells.
Neuronal cells
- Responsible for receiving, integrating, and propagating information to other cells.
- Contains three parts; dendrites, cell body, and axon(s).
- Dendrites
- Receive information from other neurons at synapses.
- Changes in dendritic spines are critical for neural plasticity that occurs during development and learning.
- Cell body
- The main synthetic and trophic center of the cell, it contains the nucleus and most organelles.
- Easily identified by a large central and euchromatic nucleus with a prominent nucleolus.
- Basophilic clumps of polyribosomes are called Nissl bodies.
- Axons
- Conducts information to muscles, glands, or neurons.
- Axons terminate at synapses.
- Dendrites
- There are a few named neurons to be aware of:
- Pyramidal Cells: The prototype cerebral neuron, present in the cortex and hippocampus, with large triangular cell bodies.
- Stellate Cells: Described as GABAergic inhibitory interneurons that control Purkinje cell activity in the cerebellum.
- Purkinje cells: Large distinct neurons in the cerebellum with a prominent pink cell body and extensive dendritic tree.
- These degenerate in various cerebellar degeneration syndromes (e.g. alcohol, chronic phenytoin use, or anti-Yo paraneoplastic syndromes).
- Purkinje cells: Large distinct neurons in the cerebellum with a prominent pink cell body and extensive dendritic tree.
Anatomy of the Neuron

- Most neurons contain multiple dendrites and only one axon.
- Neurons can be easily identified with silver staining on microscopic slides which impregnate neurofilaments.
- Intracellular neurofibrillary tangles can suggest a neurodegenerative disease such as Alzheimer’s disease.
- When the axons of a nerve are severely damaged, Wallerian degeneration occurs.
- Axonal fibers distal to the area of injury degenerate, while proximal fibers survive.
Neuron Action Potential
Move the Slider to Practice!
Log in to View the Remaining 60-90% of Page Content!
Important: If you signed up after 1/1/2026, or if you opted to migrate your old account to the new & improved platform (same great content, better experience), please log in at nowyouknowmed.com
New here? Get started!
(Or, click here to learn about our institution/group pricing)1 Month Plan
Full Access Subscription-
Access to full question bank
-
Access to all flashcards
-
Access to all chapters & site content
3 Month Plan
Full Access Subscription-
Access to full question bank
-
Access to all flashcards
-
Access to all chapters & site content
1 Year Plan
Full Access Subscription-
Access to full question bank
-
Access to all flashcards
-
Access to all chapters & site content